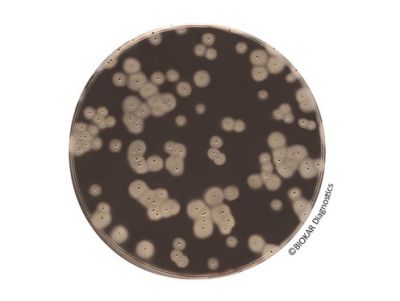
���Ͼ�������ɫ������

Easy Staph 是食品、动物饲料和环境样本中凝固酶阳性葡萄球菌计数的替代方法。由于无需确认,在标准化方法 下,该方法允许在22小时内进行致病性葡萄球菌计数,而不是通常的48小时。培养基支持使用表面接种法、倾注平板法。
该方法通过了NF验证,认证编号BKR 23/10–12/15,可用于人类消费的所有食品中凝固酶阳性葡萄球菌的检测。

包装
即用型培养基:
BM18708-20培养皿 90mm
BM19008-120培养皿 90mm
Easy Staph 试剂盒:
BT01208-6瓶190mL 基础培养基 +6份冻干补充剂
BT01308-6瓶90mL 基础培养基 +6份冻干补充剂
上一条:蜡样芽胞杆菌快速显色培养基
下一条:单增李斯特快速显色培养基